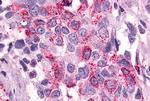
PTGER3 Antibody in Immunohistochemistry (Paraffin) (IHC (P))

Search
Invitrogen
PTGER3 Polyclonal Antibody
{{$productOrderCtrl.translations['antibody.pdp.commerceCard.promotion.promotions']}}
{{$productOrderCtrl.translations['antibody.pdp.commerceCard.promotion.viewpromo']}}
{{$productOrderCtrl.translations['antibody.pdp.commerceCard.promotion.promocode']}}: {{promo.promoCode}} {{promo.promoTitle}} {{promo.promoDescription}}. {{$productOrderCtrl.translations['antibody.pdp.commerceCard.promotion.learnmore']}}
产品信息
PA5-34121
种属反应
宿主/亚型
分类
类型
抗原
偶联物
形式
浓度
规格
纯化类型
保存液
内含物
保存条件
运输条件
RRID
产品详细信息
Percent identity with other species by BLAST analysis: Human, Gorilla, Gibbon, Monkey, Panda, Bat (100%) Mouse (94%) Xenopus (88%) Bovine, Pig, Opossum (82%).
靶标信息
CD172a, also known as signal-regulatory protein alpha, is a receptor-type transmembrane glycoprotein expressed on cells of myeloid origin, including granulocytes, dendritic cells (DCs), macrophages, mast cells and haematopoietic stem cells. CD172a acts as a substrate for several activated tyrosine kinases, including EGFR, PDGFR, src and insulin receptor and is involved in the negative regulation of receptor tyrosine kinase-coupled signaling pathways. Ligand binding of CD172a to integrin-associated protein CD47, results in tyrosine kinase phosphorylation of immunoreceptor tyrosine-based inhibitory motifs (ITIMs) within the cytoplasmic region of CD172a, mediating the recruitment and activation of the tyrosine phosphatases SHP-1 and SHP-2. These then act as regulators of cellular function, through dephosphorylation of specific substrates. Ligation of CD172a with CD47 has been demonstrated in several regulatory processes, including the inhibition of host cell phagocytosis by macrophages and the bi-directional activation of T cells and DCs.
仅用于科研。不用于诊断过程。未经明确授权不得转售。
篇参考文献 (0)
生物信息学
蛋白别名: EP3 prostanoid receptor EP3-III isoform; Ep3 receptor; G-protein coupled receptor; PTGER3; MGC141828; MGC141829; MGC27302; PGE receptor EP3 subtype; PGE receptor, EP3 subtype; PGE2 receptor EP3 subtype; PGE2 receptor splice variant; isoform EP3-I; PGE2-R; pr; prostaglandin E receptor 3 (subtype EP3); Prostaglandin E2 receptor EP3 subtype; prostaglandin receptor (PGE-2); Prostanoid EP3 receptor; unnamed protein product
基因别名: EP3; EP3-I; EP3-II; EP3-III; EP3-IV; EP3-VI; EP3e; lnc003875; PGE2-R; PTGER3
UniProt ID: (Human) P43115
Entrez Gene ID: (Human) 5733